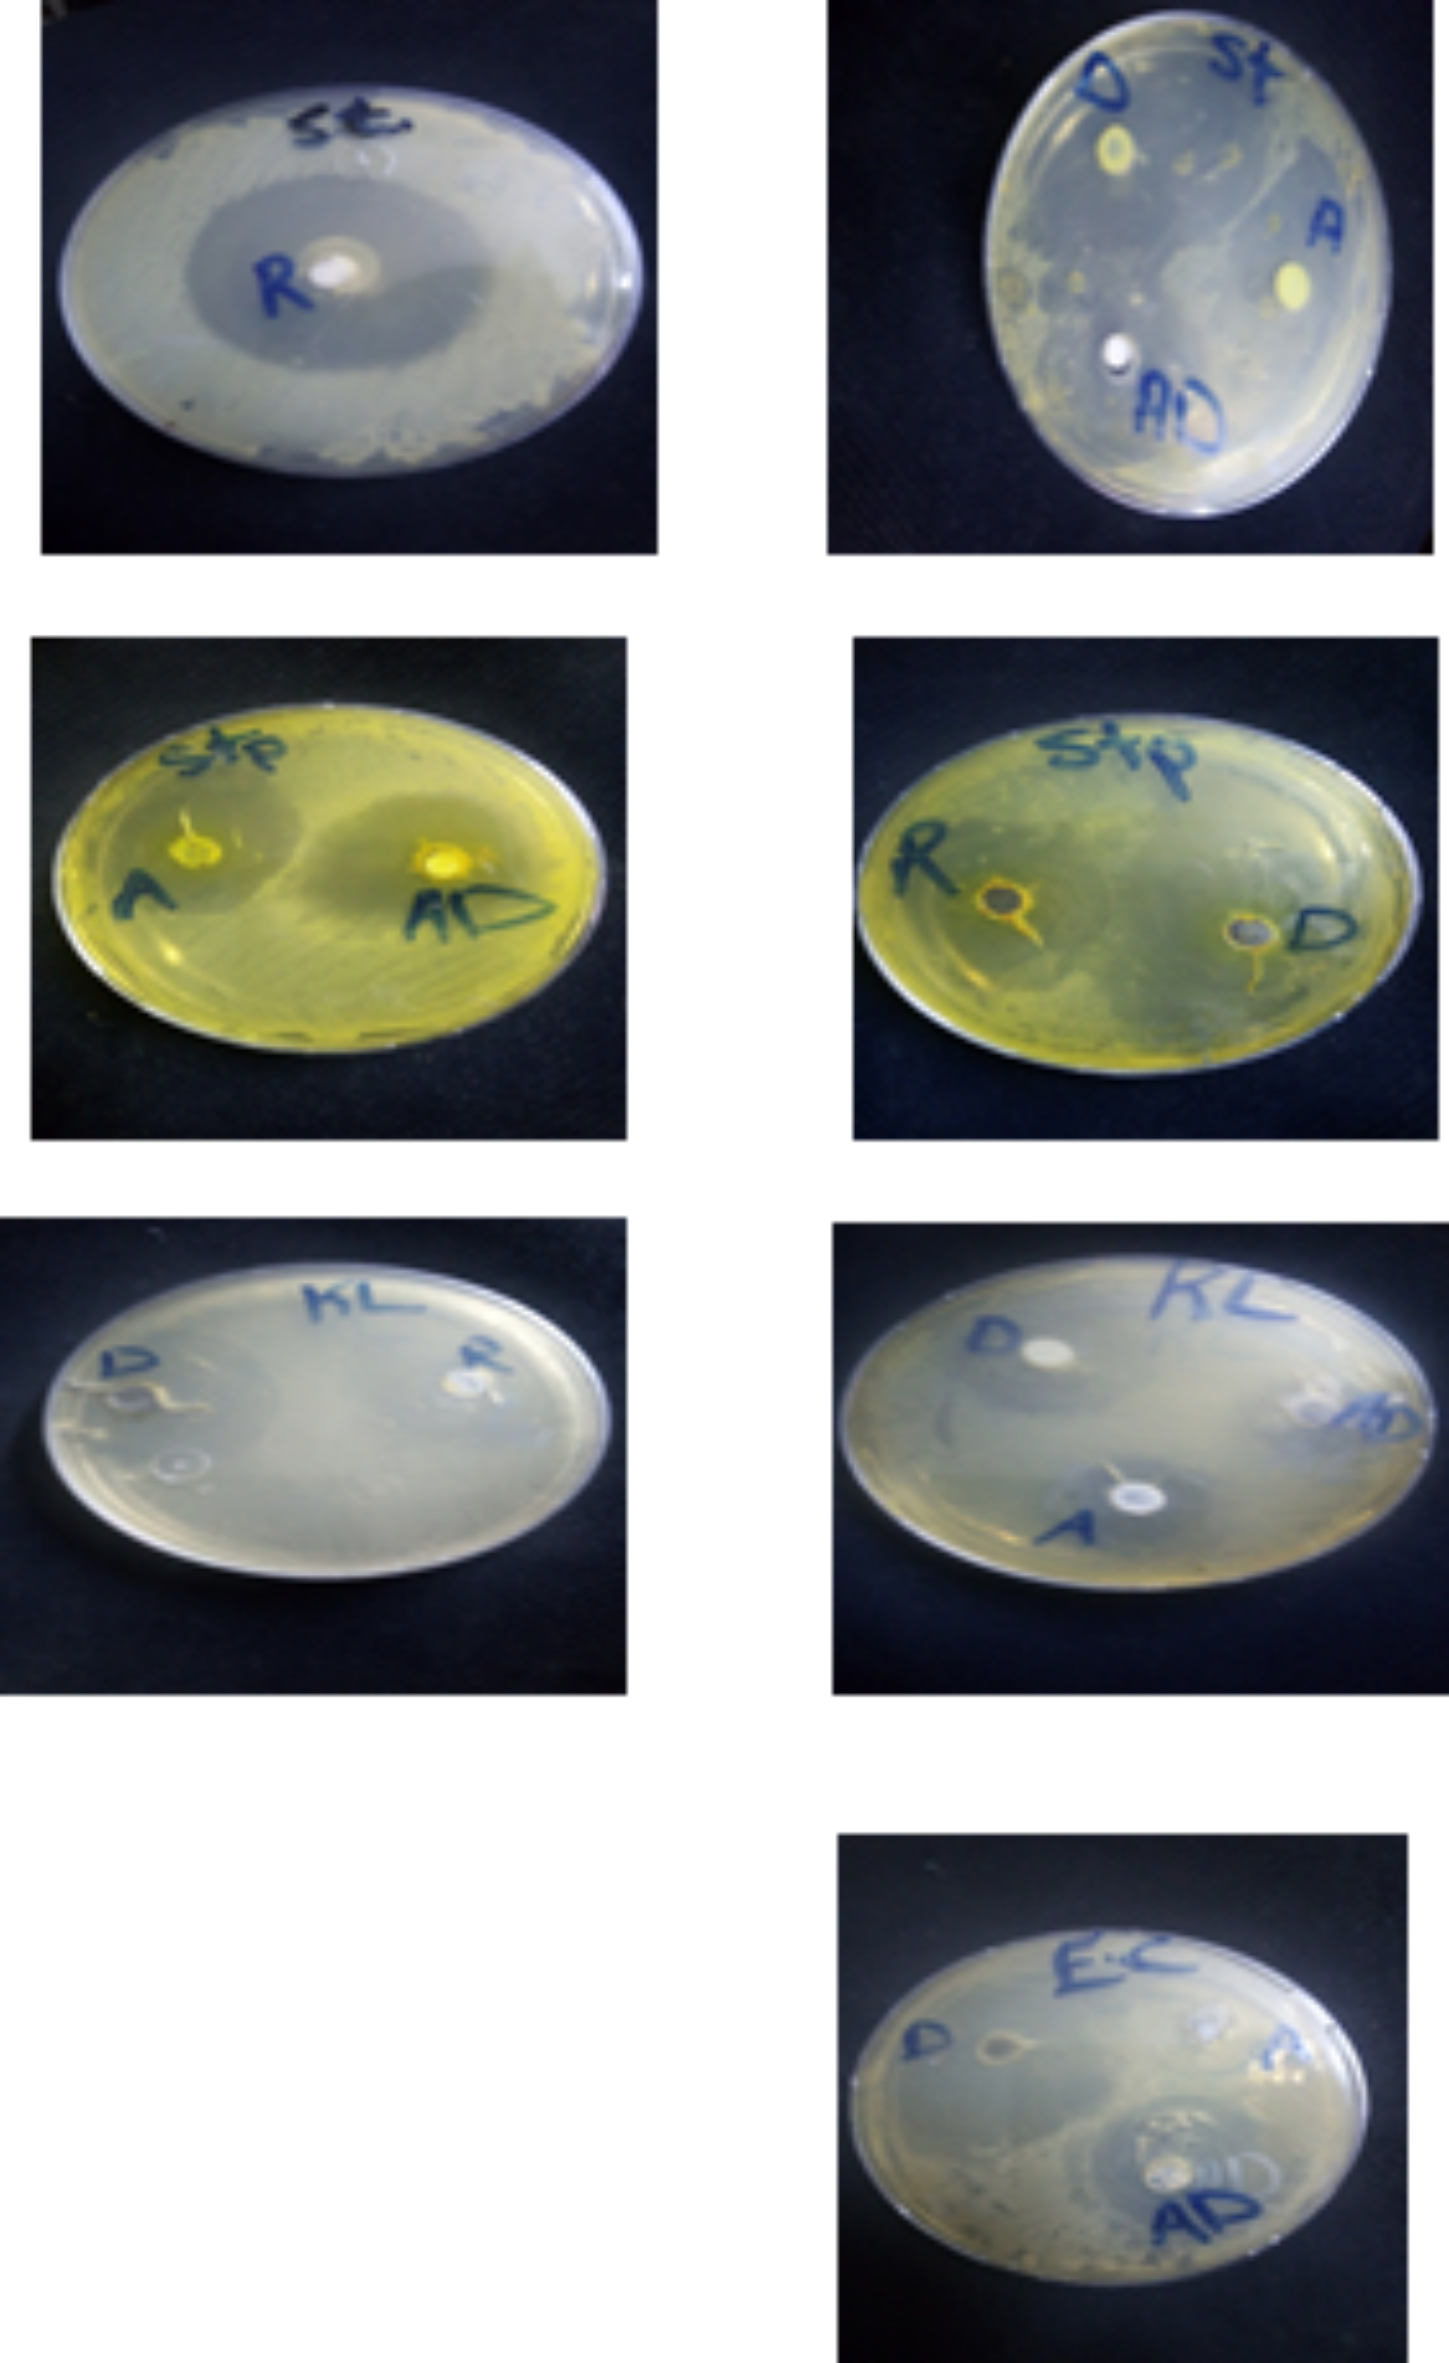
Fig. 5

Fig. 5

Images of disc diffusion results of AgNPs (A), Doxy (D) and Doxy loaded AgNPs(AD), (R) is stander drug on Klebsiella pneumonia(KL), Staphylococcus aureus(ST), Escherichia coli(EC) and Streptococcus mutans(STP).
Images of disc diffusion results of AgNPs (A), Doxy (D) and Doxy loaded AgNPs(AD), (R) is stander drug on Klebsiella pneumonia(KL), Staphylococcus aureus(ST), Escherichia coli(EC) and Streptococcus mutans(STP).